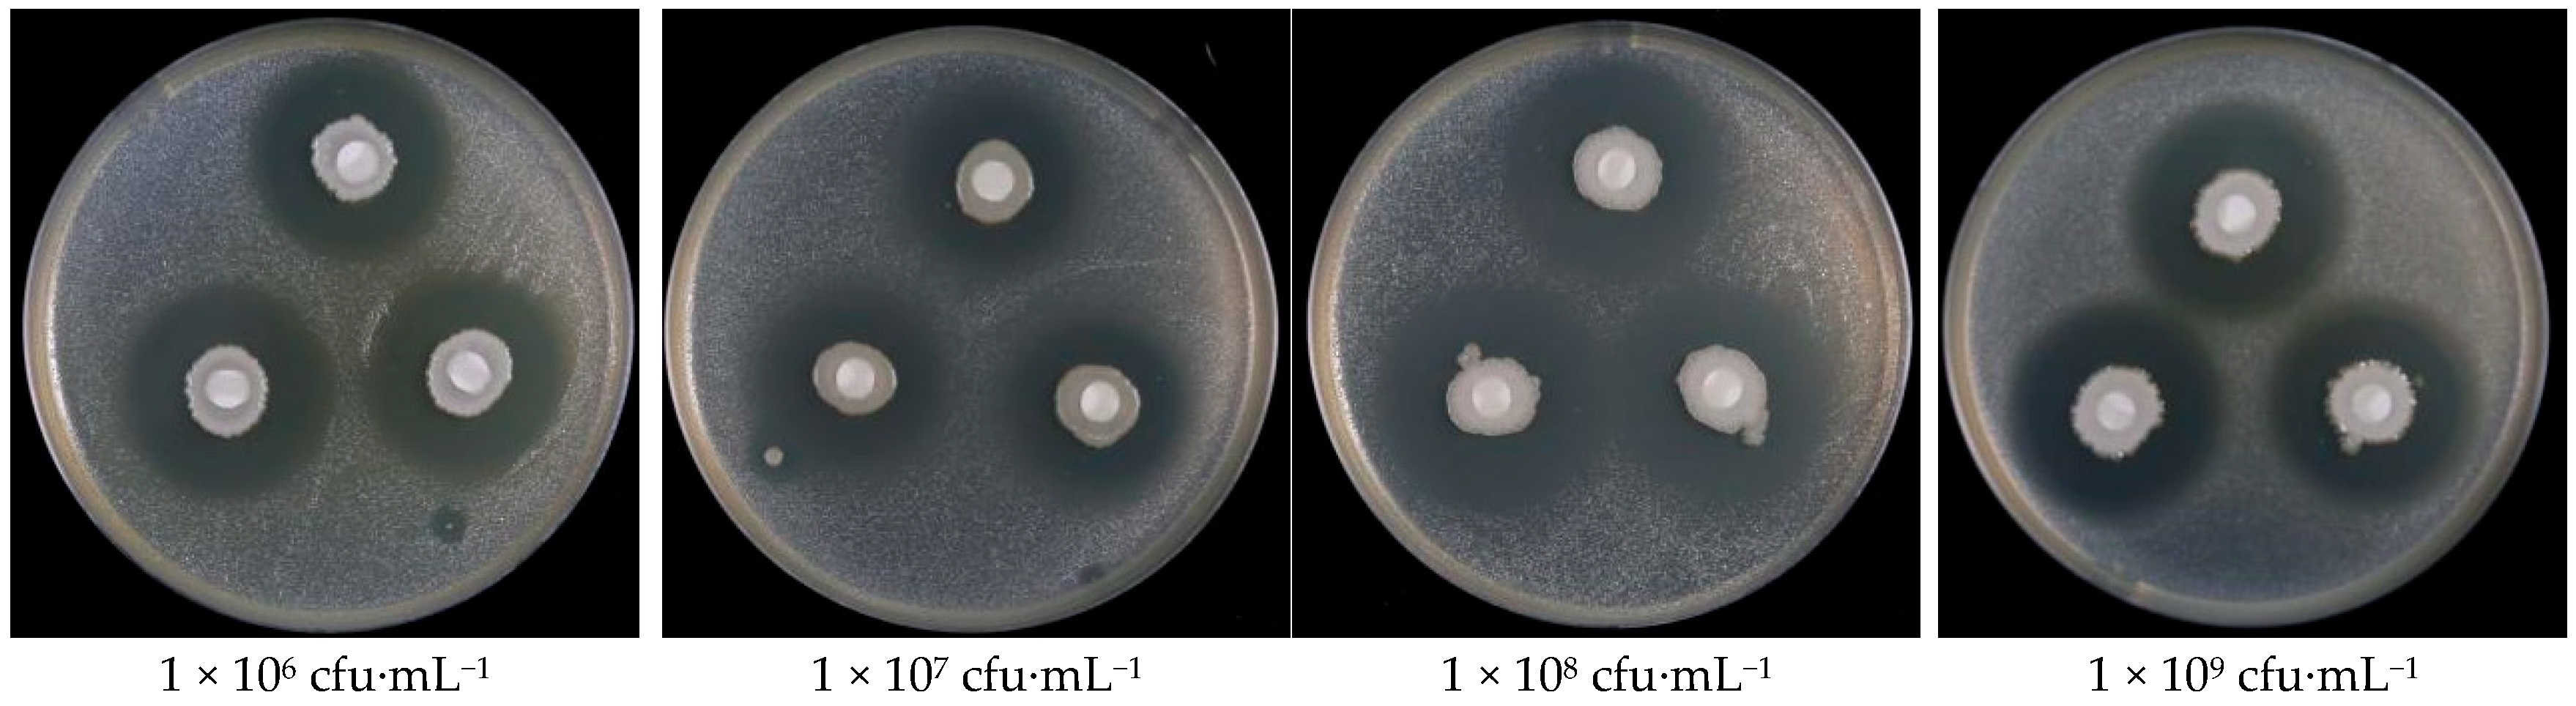
Agronomy 14 02797 g002

Synergistic Control of Bacterial Fruit Blotch Using Bacillus velezensis ZY1 and Chemical Bactericides
Abstract
1. Introduction
2. Materials and Methods
2.1. Materials and Bactericides
2.2. Indoor Toxicity Determination of Test Agents and ZY1 Against pslb65
2.3. Determination of Biocompatibility of ZY1 with Chemical Agents
2.4. Laboratory Toxicity Determination of the Compound Against Acidovorax Citrulli
2.5. Determination of the Efficacy of the Compound Against BFB in Beijing Greenhouse
2.6. Field Trial
2.6.1. Determination of Field Efficacy of Compound Against BFB in Hainan Province
2.6.2. Determination of Field Efficacy of Compound Agent Against BFB in Xinjiang
2.7. Data Statistics and Analysis
3. Results
3.1. Toxicity Analysis of 10 Chemical Agents and ZY1 Against A. citrulli
3.2. Compatibility Analysis of Biocontrol Agent ZY1 Strain with the Tested Agents
3.3. Indoor Toxicity Test of the Combination of Zhongshengmycin, Zhongsheng Tetramycin Solution, and Biocontrol Agent ZY1
3.4. Control Effects of Chemical Agents and B. velezensis ZY1 on BFB in Greenhouses
3.5. Control Effects of Chemical Agents and Bacillus velezensis ZY1 on BFB in the Fields
3.5.1. Field Trial in Hainan Province
3.5.2. Field Trial in Xinjiang Uygur Autonomous Region
4. Discussion
Supplementary Materials
Author Contributions
Funding
Data Availability Statement
Conflicts of Interest
References
- Webb, R.E.; Goth, R.W. A seedborae bacterium isolated from Watermelon. Plant Dis. Rep. 1965, 49, 818–821. [Google Scholar]
- Burdman, S.; Walcott, R.O.N. Acidovorax citrulli: Generating basic and applied knowledge to tackle a global threat to the cucurbit industry. Mol. Plant Pathol. 2012, 13, 805–815. [Google Scholar] [CrossRef]
- Ji, W.Q.; Ye, Y.F.; Zhang, A.P.; Yang, Y.W.; Guan, W.; Zhao, T.C. Advances of bacterial fruit blotch in China. China Cucurbits Veg. 2022, 35, 1–8. [Google Scholar]
- Zhao, W.L.; Yang, Y.W.; Wang, T.L.; Jiang, J.; Liu, H.Q.; Zhao, T.C. Sensitivity test and analysis of Acidovorax citrulli to copper sulfate. Plant Prot. 2013, 39, 100–105. [Google Scholar]
- Walcott, R.R.; Fessehaie, A.; Castro, A.C. Differences in pathogenicity between two genetically distinct groups of Acidovorax avenae subsp. citrulli on cucurbit hosts. J. Phytopathol. 2004, 152, 277–285. [Google Scholar] [CrossRef]
- Adhikari, M.; Kim, S.W.; Um, Y.H.; Kim, H.S.; Lee, S.C.; Song, J.Y.; Lee, Y.S. Biological control of bacterial fruit blotch of watermelon pathogen (Acidovorax citrulli) with rhizosphere associated bacteria. Plant Pathol. J. 2017, 33, 170. [Google Scholar] [CrossRef]
- Collinge, D.B.; Jensen, D.F.; Rabiey, M.; Sarrocco, S.; Shaw, M.W.; Shaw, R.H. Biological control of plant diseases—What has been achieved and what is the direction? Plant Pathol. 2022, 71, 1024–1047. [Google Scholar] [CrossRef]
- Shi, Y.; Yang, L.; Wang, X.; Gao, Y.; Liu, W.; Lou, K. Biocontrol of bacterial spot diseases of muskmelon using Paenibacillus polymyxa G-14. Afr. J. Biotechnol. 2012, 11, 16845–16851. [Google Scholar]
- Fan, H.; Zhang, Z.; Li, Y.; Zhang, X.; Duan, Y.; Wang, Q.I. Biocontrol of bacterial fruit blotch by Bacillus subtilis 9407 via surfactin-mediated antibacterial activity and colonization. Front. Microbiol. 2017, 8, 1973. [Google Scholar] [CrossRef]
- Bonaterra, A.; Badosa, E.; Daranas, N.; Francés, J.; Roselló, G.; Montesinos, E. Bacteria as Biological Control Agents of Plant Diseases. Microorganisms 2022, 10, 1759. [Google Scholar] [CrossRef]
- Huang, H.J.; Luo, K. Research progress in the control of plant diseases by the combination of Bacillus and fungicides. Microbiology 2021, 48, 938–947. [Google Scholar]
- Anand, T.; Chandrasekaran, A.; Kuttalam, S.; Senthilraja, G.; Samiyappan, R. Integrated control of fruit rot and powdery mildew of chilli using the biocontrol agent Pseudomonas fluorescens and a chemical fungicide. Biol. Control 2010, 52, 1–7. [Google Scholar] [CrossRef]
- Liu, L.; Liang, M.; Li, L.; Sun, L.; Xu, Y.; Gao, J.; Huang, S. Synergistic effects of the combined application of Bacillus subtilis H158 and strobilurins for rice sheath blight control. Biol. Control 2018, 117, 182–187. [Google Scholar] [CrossRef]
- Ji, X.; Li, J.; Meng, Z.; Zhang, S.; Dong, B.; Qiao, K. Synergistic effect of combined application of a new fungicide fluopimomide with a biocontrol agent Bacillus methylotrophicus TA-1 for management of gray mold in tomato. Plant Dis. 2019, 103, 1991–1997. [Google Scholar] [CrossRef]
- Omar, I.; O’neill, T.M.; Rossall, S. Biological control of Fusarium crown and root rot of tomato with antagonistic bacteria and integrated control when combined with the fungicide carbendazim. Plant Pathol. 2006, 55, 92–99. [Google Scholar] [CrossRef]
- Peng, D.; Li, S.; Chen, C.; Zhou, M. Combined application of Bacillus subtilis NJ-18 with fungicides for control of sharp eyespot of wheat. Biol. Control 2014, 70, 28–34. [Google Scholar] [CrossRef]
- Ji, W.Q.; Yang, Y.W.; Liu, D.H.; Wang, C.L.; Yu, C.Y.; Guan, W.; Zhao, T.C. Complete Genome Sequence of Bacillus velezensis Strain ZY1, a Potential Biological Control Agent for Bacterial Fruit Blotch. PhytoFrontiers™ 2023, 3, 734–737. [Google Scholar] [CrossRef]
- Cai, F.; Yang, C.; Ma, T.; Osei, R.; Jin, M.; Zhang, C.; Wang, Y. An endophytic Paenibacillus polymyxa hg18 and its biocontrol potential against Fusarium oxysporum f. sp. cucumerinum. Biol. Control 2023, 188, 105380. [Google Scholar] [CrossRef]
- Chen, F.L.; Zheng, P.N.; Wang, Y. A trial design about bioassay of insecticide mixed. Pestic. Sci. Adm. 1997, 18, 30–31. [Google Scholar]
- Wang, T.; Guan, W.; Huang, Q.; Yang, Y.; Yan, W.; Sun, B.; Zhao, T. Quorum-sensing contributes to virulence, twitching motility, seed attachment and biofilm formation in the wild type strain Aac-5 of Acidovorax citrulli. Microb. Pathog. 2016, 100, 133–140. [Google Scholar] [CrossRef]
- Ji, W.; Zhao, M.; Fei, N.; Yang, L.; Qiao, P.; Walcott, R.; Zhao, T. Essential Acidovorax citrulli virulence gene hrpE activates host immune response against pathogen. Int. J. Mol. Sci. 2022, 23, 9144. [Google Scholar] [CrossRef] [PubMed]
- Fei, N.Y.; Chen, H.M.; Yang, Y.W.; Guan, W.; Liu, B.Y.; Zhao, T.C. Advances of cucurbit bacterial fruit blotch abroad. China Cucurbits and Vegetables. Chin. Melons Veg. 2022, 35, 1–8. [Google Scholar]
- Dong, C.L.; Yang, Y.W.; Sun, B.X.; Wang, T.L.; Zhe, D.M.; Zhao, T.C.; Gao, J. Effect of chemical treatments on germination of triploid watermelon seeds and control to bacterial fruit blotch. Plant Prot. 2015, 41, 178–184. [Google Scholar]
- Chen, H.Y.; Chen, M.C.; Qin, S.; Xiao, M.; Ji, X.C. Efficiency Test of Fungicides against Bacterial Fruit Blotch of Melon in Hainan Island. J. Change Veg. 2012, 2, 3. [Google Scholar]
- Shin, H.J.; Kim, H.; Beuchat, L.R.; Ryu, J.H. Antimicrobial activities of organic acid vapors against Acidovorax citrulli, Salmonella enterica, Escherichia coli O157: H7, and Listeria monocytogenes on Cucurbitaceae seeds. Food Microbiol. 2020, 92, 103569. [Google Scholar] [CrossRef]
- Khedher, S.B.; Mejdoub-Trabelsi, B.; Tounsi, S. Biological potential of Bacillus subtilis V26 for the control of Fusarium wilt and tuber dry rot on potato caused by Fusarium species and the promotion of plant growth. Biol. Control 2021, 152, 104444. [Google Scholar] [CrossRef]
- Huang, J.; Wei, Z.; Tan, S.; Mei, X.; Yin, S.; Shen, Q.; Xu, Y. The rhizosphere soil of diseased tomato plants as a source for novel microorganisms to control bacterial wilt. Appl. Soil Ecol. 2013, 72, 79–84. [Google Scholar] [CrossRef]
- Jacobsen, B.J.; Zidack, N.K.; Larson, B.J. The role of Bacillus-based biological control agents in integrated pest management systems: Plant diseases. Phytopathology 2004, 94, 1272–1275. [Google Scholar] [CrossRef]
- Thakur, N.; Kaur, S.; Tomar, P.; Thakur, S.; Yadav, A.N. Microbial biopesticides: Current status and advancement for sustainable agriculture and environment. In New and Future Developments in Microbial Biotechnology and Bioengineering; Elsevier: Amsterdam, The Netherlands, 2020; pp. 243–282. [Google Scholar]
- Peng, D.; Luo, K.; Jiang, H.; Deng, Y.; Bai, L.; Zhou, X. Combined use of Bacillus subtilis strain B-001 and bactericide for the control of tomato bacterial wilt. Pest Manag. Sci. 2017, 73, 1253–1257. [Google Scholar] [CrossRef]
- Liu, Y.; Chen, Z.; Liu, Y.; Wang, X.; Luo, C.; Nie, Y.; Wang, K. Enhancing bioefficacy of Bacillus subtilis with sodium bicarbonate for the control of ring rot in pear during storage. Biol. Control 2011, 57, 110–117. [Google Scholar] [CrossRef]
- Peng, D.; Li, S.; Wang, J.; Chen, C.; Zhou, M. Integrated biological and chemical control of rice sheath blight by Bacillus subtilis NJ-18 and jinggangmycin. Pest Manag. Sci. 2014, 70, 258–263. [Google Scholar] [CrossRef] [PubMed]
- Frances, J.; Bonaterra, A.; Badosa, E.; Montesinos, E. Combination of Pseudomonas fluorescens EPS288 and reduced fungicide dose for control of Penicillium rot during postharvest storage of pear. Acta Hortic. 2002, 596, 883–886. [Google Scholar] [CrossRef]
- Arjona-Lopez, J.M.; Tienda, S.; Arjona-Girona, I.; Cazorla, F.M.; Lopez-Herrera, C.J. Combination of low concentrations of fluazinam and antagonistic rhizobacteria to control avocado white root rot. Biol. Control 2019, 136, 103996. [Google Scholar] [CrossRef]
- Kondoh, M.; Hirai, M.; Shoda, M. Integrated biological and chemical control of damping-off caused by Rhizoctonia solani using Bacillus subtilis RB14-C and flutolanil. J. Biosci. Bioeng. 2001, 91, 173–177. [Google Scholar] [CrossRef]
- Brannen, P.M.; Kenney, D.S. Kodiak®—A successful biological-control product for suppression of soil-borne plant pathogens of cotton. J. Ind. Microbiol. Biotechnol. 1997, 19, 169–171. [Google Scholar] [CrossRef]
- Sowndhararajan, K.; Marimuthu, S.; Manian, S. Integrated control of blister blight disease in tea using the biocontrol agent Ochrobactrum anthropi strain BMO-111 with chemical fungicides. J. Appl. Microbiol. 2013, 114, 1491–1499. [Google Scholar] [CrossRef]
- Korsten, L.; De Villiers, E.E.; Wehner, F.C.; Kotzé, J.M. Field sprays of Bacillus subtilis and fungicides for control of preharvest fruit diseases of avocado in South Africa. Plant Dis. 1997, 81, 455–459. [Google Scholar] [CrossRef]
- Zeng, W.; Kirk, W.; Hao, J. Field management of Sclerotinia stem rot of soybean using biological control agents. Biol. Control 2012, 60, 141–147. [Google Scholar] [CrossRef]

| Serial Number | Name of the Medicine | Lowest Concentration (mg·mL−1) | Optimal Concentration (mg·mL−1) | Maximum Concentration (mg·mL−1) |
|---|---|---|---|---|
| 1 | Prothioconazole | 1.11 | 1.43 | 2 |
| 2 | Zhongsheng Tetramycin Solution | 1.67 | 2 | 2.5 |
| 3 | Tetramycin Oxine–copper | 0.56 | 0.67 | 0.83 |
| 4 | Streptomycin Sesquisulfate | 0.83 | 1 | 1.25 |
| 5 | Tetramycin | 1.25 | 1.67 | 2.5 |
| 6 | Thiodiazole–copper | 1.43 | 2 | 3.33 |
| 7 | Copper hydroxide | 0.56 | 0.67 | 0.83 |
| 8 | Zhongshengmycin Kasugamycin | 0.67 | 0.83 | 1 |
| 9 | Kasugamycin | 0.56 | 0.67 | 0.83 |
| 10 | Zhongshengmycin | 0.56 | 0.67 | 0.83 |
| Treatment | Eficacy Regression Equation | EC50/(mg·L−1) |
|---|---|---|
| Prothioconazole | y = 1.5508x − 1.9137 | 17.140 |
| Zhongsheng Tetramycin Solution | y = 1.2577x − 2.4816 | 93.984 |
| Tetramycin Oxine–copper | — | — |
| Streptomycin Sesquisulfate | y = 1.3627x − 1.8781 | 23.891 |
| Tetramycin | y = 0.9097x − 2.2811 | 321.773 |
| Thiodiazole–copper | — | — |
| Copper Hydroxide | — | — |
| Zhongshengmycin Kasugamycin | — | — |
| Kasugamycin | — | — |
| Zhongshengmycin | y = 0.9621x − 1.4664 | 33.427 |
| ZY1 Concentration/(cfu·mL−1) | Colony Diameter/mm | Inhibition Rate/% |
|---|---|---|
| 1 × 106 | 25.11 ± 0.38 c | 27.90% c |
| 1 × 107 | 27.33 ± 1.00 b | 30.37% b |
| 1 × 108 | 30.33 ± 1.20 a | 33.70% a |
| 1 × 109 | 31.67 ± 0.58 a | 35.19% a |
| CK | 0 | — |
| Treatment | Concentration (mg·mL−1) | Bacterial Growth | Colony Number |
|---|---|---|---|
| Prothioconazole | 2 | × | — |
| 1.43 | × | — | |
| 1.11 | × | — | |
| ZhongshengTetramycin Solution | 2.5 | + | 8 ± 2.887 |
| 2 | + | 157 ± 20.43 | |
| 1.67 | +++ | 141 ± 37.501 | |
| Streptomycin Sesquisulfate | 1.25 | + | 12 ± 1.732 |
| 1 | + | 6 ± 1.528 | |
| 0.83 | × | — | |
| Tetramycin | 2.5 | + | 1 ± 0.577 |
| 1.67 | + | 4 ± 2.082 | |
| 1.25 | ++ | 21 ± 13.65 | |
| Kasugamycin | 0.83 | +++ | 92 ± 21.825 |
| 0.67 | +++ | 91 ± 25.813 | |
| 0.56 | ++ | 58 ± 16.093 | |
| Zhongshengmycin | 0.83 | ++ | 85 ± 24.88 |
| 0.67 | ++ | 81 ± 31.896 | |
| 0.56 | ++ | 83 ± 13.614 | |
| CK | +++ | 89 ± 35.501 |
| VZhongshengmycin:VZY1 | Colony Diameter/mm | Actual Inhibition Rate/% | Theoretical Inhibition Rate/% | IR |
|---|---|---|---|---|
| 0:10 | 25.22 ± 1.07 bc | 28.03% bcd | 28.03% | — |
| 1:9 | 24.22 ± 2.84 c | 26.91% cd | 27.01% | 0.996 |
| 2:8 | 24.22 ± 1.95 c | 26.91% cd | 25.98% | 1.036 |
| 3:7 | 28.11 ± 4.22 b | 31.23% abc | 24.96% | 1.251 |
| 4:6 | 29 ± 1.86 ab | 32.22% ab | 23.93% | 1.346 |
| 5:5 | 31.78 ± 0.19 a | 35.31% a | 22.91% | 1.542 |
| 6:4 | 30.33 ± 1.21 ab | 33.70% a | 21.88% | 1.540 |
| 7:3 | 25.11 ± 1.58 bc | 27.90% bcd | 20.86% | 1.337 |
| 8:2 | 21.22 ± 2.99 c | 23.58% d | 19.83% | 1.189 |
| 9:1 | 16.56 ± 0.51 d | 18.40% e | 18.81% | 0.978 |
| 10:0 | 16 ± 0.33 d | 17.78% e | 17.78% | — |
| VZhongsheng Tetramycin Solution:VZY1 | Colony Diameter/mm | Actual Inhibition Rate/% | Theoretical Inhibition Rate/% | IR |
|---|---|---|---|---|
| 0:10 | 24.89 ± 1.02 ab | 27.66% ab | 27.66% | — |
| 1:9 | 25.55 ± 1.35 ab | 28.39% a | 25.92% | 1.095 |
| 2:8 | 24.22 ± 2.59 ab | 26.91% ab | 24.17% | 1.113 |
| 3:7 | 24.33 ± 1.45 ab | 27.04% ab | 22.43% | 1.206 |
| 4:6 | 20.22 ± 1.26 b | 22.47%b | 20.68% | 1.807 |
| 5:5 | 23.39 ± 3.27 ab | 25.99% ab | 18.94% | 1.372 |
| 6:4 | 27.22 ± 0.39 a | 30.25% a | 17.20% | 1.759 |
| 7:3 | 24.33 ± 2.6 ab | 27.04% ab | 15.45% | 1.750 |
| 8:2 | 23.56 ± 6.45 ab | 26.17% ab | 13.71% | 1.901 |
| 9:1 | 22.56 ± 1.39 b | 25.06% ab | 11.96% | 2.095 |
| 10:0 | 9.2 ± 0.17 c | 10.22% c | 10.22% | — |
Disclaimer/Publisher’s Note: The statements, opinions and data contained in all publications are solely those of the individual author(s) and contributor(s) and not of MDPI and/or the editor(s). MDPI and/or the editor(s) disclaim responsibility for any injury to people or property resulting from any ideas, methods, instructions or products referred to in the content. |
© 2024 by the authors. Licensee MDPI, Basel, Switzerland. This article is an open access article distributed under the terms and conditions of the Creative Commons Attribution (CC BY) license (https://creativecommons.org/licenses/by/4.0/).
Share and Cite
Wei, H.; Han, S.; Mijiti, M.; Zhao, T.; Guan, W.; Yang, Y. Synergistic Control of Bacterial Fruit Blotch Using Bacillus velezensis ZY1 and Chemical Bactericides. Agronomy 2024, 14, 2797. https://doi.org/10.3390/agronomy14122797
Wei H, Han S, Mijiti M, Zhao T, Guan W, Yang Y. Synergistic Control of Bacterial Fruit Blotch Using Bacillus velezensis ZY1 and Chemical Bactericides. Agronomy. 2024; 14(12):2797. https://doi.org/10.3390/agronomy14122797
Chicago/Turabian StyleWei, Haoyu, Sheng Han, Maihemuti Mijiti, Tingchang Zhao, Wei Guan, and Yuwen Yang. 2024. "Synergistic Control of Bacterial Fruit Blotch Using Bacillus velezensis ZY1 and Chemical Bactericides" Agronomy 14, no. 12: 2797. https://doi.org/10.3390/agronomy14122797
APA StyleWei, H., Han, S., Mijiti, M., Zhao, T., Guan, W., & Yang, Y. (2024). Synergistic Control of Bacterial Fruit Blotch Using Bacillus velezensis ZY1 and Chemical Bactericides. Agronomy, 14(12), 2797. https://doi.org/10.3390/agronomy14122797

